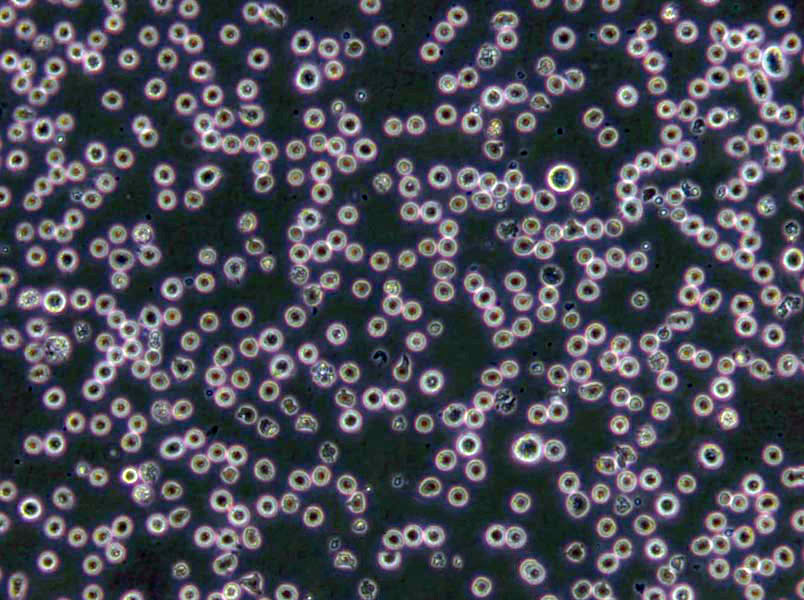
ID8 Cells|小鼠卵巢癌需消化细胞系

"ID8 Cells|小鼠卵巢癌需消化细胞系
Cell形态:上皮Cell样
Cell生长:贴壁
【Cell培养中细菌、霉菌的污染情况总结】细菌:细菌在普通倒置显微镜下为黑色细沙状,根据感染细菌的不同,可有不同的外形,培养液一般会浑浊变黄,对Cell生长影响明显。仔细检查一下器皿的灭菌情况,是否在GAO压灭菌时放气时间足够,压力足够!尤其是和储存培养液接触的移液管等物品,连续两次污染的话有可能造成储存液污染,一定要注意!下次使用前检查一下培养液是否存在浑浊的现象!可在培养液中加相应的抗生素处理;霉菌:培养液是清亮的,倒置显微镜下无杂质,37度孵箱培养2-3天,仍清亮,但出现絮状杂质,镜下可见呈细丝状的团状漂浮物,可看到明显的菌丝,Cell仍可生长,但时间长之后,Cell的活力状态变差,用酸铜溶液擦拭CO2孵箱内,再把水盘里也加上饱和量的酸铜。或者在培养箱的托盘加入饱和的消毒二钠GAO盐液体,可以防止霉菌污染。CO2孵箱被霉菌污染后,可把所有Cell暂时转移,采用擦洗孵箱(包括隔板,箱壁)。并把放置在孵箱内一个小时,使其蒸汽弥漫。待的气味消散后,再移入Cell。孵箱应定期清洁(2月左右),尤其在多雨的季节。其它培养箱清洗方法是:用84液擦洗-清水擦洗-75%酒精擦洗-紫外灯照。预防霉菌污染,可在培养基里加3u/ml的两性霉素或制霉菌素或D或双抗;但Cell一旦污染,很难挽救,制霉菌素或D或双抗都于事无补,建议舍弃该污染Cell,将环境彻底消毒,如果所有Cell都污染,可能是系统污染,检查一下培养基和器材,如果只是个别污染,可能是操作问题,就要注意操作。
ID8 Cells|小鼠卵巢癌需消化细胞系
Cell物种来源:或鼠源等其它物种来源
C81-61Cells;Cell背景资料:皮肤黑色素瘤;腹壁转移;女性;Cell传代方法:1:2-1:3传代;每周换液2-3次。;Cell生长特性:贴壁;Cell形态特性:详见Cell说明书;相关Cell有:JB 6Cells、Hs 445Cells、Panc8.13Cell
C81-61Cells;Cell背景资料:皮肤黑色素瘤;腹壁转移;女性;Cell传代方法:1:2-1:3传代;每周换液2-3次。;Cell生长特性:贴壁;Cell形态特性:详见Cell说明书;相关Cell有:JB 6Cells、Hs 445Cells、Panc8.13Cell
U-343 MGCells;Cell背景资料:详见相关文献介绍;Cell传代方法:1:2传代;Cell生长特性:贴壁生长 ;Cell形态特性:详见Cell说明书;相关Cell有:MGH-U3 (RN)Cells、H735Cells、H1385Cell
[Cell产品包装]鲜活Cell:T25培养瓶(一瓶)或冻存Cell:1ml冻存管(两支)
Cell背景资料:详见相关文献介绍
Cell传代方法:1:2传代
在Cell培养过程中会出现这样或那样的问题,客户遇到的问题从Cell生长角度来说,针对Cell培养过程中生长不HAO、甚至死亡的原因,我们做以下分析并提出相对应的解决方法。一、培养Cell生长不HAO》可能原因:Cell本身的状态》1)Cell传代次数多,Cell老化;2)Cell的接种量:接种量过低,Cell生长缓慢;3)Cell传代时间过晚:Cell中毒,影响传代后的Cell生长;4)胰酶消化时间过长或过短:时间过长,Cell死亡;时间过短,Cell未完全分离而成团,Cell死亡;5)Cell的冻存与复苏:慢冻速融。污染:1)支原体污染;2)霉菌污染;培养基或血清:1)更换血清或培养基之前未进行验证;2)选择的培养基是否合适;3)培养基配制是否准确无误;培养环境:1)CO2供应是否正常;2)培养箱或摇床温度控制是否正确;解决方法:根据以上四个方面的可能原因,做出针对性的解决方案》1)注意Cell的本身状态:如传代次数、接种量等;2)避免产生污染(用正规、合法、可溯源的血清);3)要用合适的血清或培养基,ZuiHAO经过验证;4)注意实验室的环境;二、培养Cell死亡》可能原因:1)培养箱内无CO2;2)培养箱内温度波动太大;3)Cell冻存或复苏过程中损伤;4)培养液渗透压不正确;5)培养液中有毒代谢产物堆积;解决方法:1)检测培养箱内CO2;2)检查培养箱内温度;3)取新的保存Cell种;4)检测培养液渗透压;5)换入新鲜培养液。
ID8 Cells|小鼠卵巢癌需消化细胞系
Cell来源说明:来源于RCB、ATCC、KCLB、DSMZ、ECACC、INCell、ScienCell、ECACC、JCRB、Asterand、ICLC等知名Cell库
HT-115Cells;Cell背景资料:结肠癌;Cell传代方法:1:2-1:3传代;每周换液2-3次。;Cell生长特性:贴壁;Cell形态特性:详见Cell说明书;相关Cell有:32D.3Cells、HSMCCells、A-172 MGCell
TE15Cells;Cell背景资料:详见相关文献介绍;Cell传代方法:1:2-1:3传代;每周换液2-3次。;Cell生长特性:贴壁或悬浮,详见Cell说明书部分;Cell形态特性:详见Cell说明书;相关Cell有:N-Tera-2Cells、PAECCells、4T1-LUCCell
Tu-686Cells;Cell背景资料:详见相关文献介绍;Cell传代方法:1:2传代;Cell生长特性:贴壁生长 ;Cell形态特性:详见Cell说明书;相关Cell有:HEK-AD 293Cells、Tohoku Hospital Pediatrics-1Cells、ROS 17/2.8Cell
Cell生长特性:贴壁生长
Cell培养实验中常见问题总结:1)一般客户拿到Cell后,应该注意什么?客户收到Cell后先不开盖,放在培养箱静置若干小时后(看Cell密度而定)在倒置显微镜下观察Cell生长情况,并对Cell进行不同倍数拍照(建议受收Cell后观察培养基的颜色和是否有漏液情况,显微镜下拍Cell100X,200X各一张),排除Cell本身污染的情况;收到Cell未开封,出现污染状况我们负责免费发送一株Cell。收到Cell时如无异常情况,请在显微镜下观察Cell密度,如为贴壁Cell,未超过80%汇合度时,将培养瓶中培养液吸出,留下10ml培养液继续培养;超过80%汇合度时,请按Cell培养条件传代培养。如为悬浮Cell,吸出培养液、1000转/分钟离心2分钟,吸出上清,管底Cell用新鲜培养基悬浮Cell后移回培养瓶。Cell消化液建议使用PBS配制,慎用Hanks液配制;2)快递Cell多久能到,是寄冻存的Cell还是复苏HAO的Cell?我们采用快递发货,一般外地2--3天,寄Cell前请确认当地温度,如果气温低于4度的,则采用邮寄冻存Cell;3)可否使用与原先培养条件不同之培养基?不能。每一Cell株均有其定使用且已适应之Cell培养基,若骤然使用和原先提供之培养条件不同之培养基,Cell大都无法立即适应,造成Cell无法存活;4)可否使用与原先培养条件不同之血清种类?不能。血清是Cell培养上一个极为重要的营养来源,所以血清的种类和品质对于Cell的生长会产生极大的影响。来自不同物种的血清,在一些物质或分子的量或内容物上都有所不同,血清使用错误常会造成Cell无法存活。
MHCC 97-HCell类似产品::NIT-1Cell、SW-626Cell、16HBEo-Cell
RPMCCell类似产品::RA-FLSsCell、NeHepLxHTCell、H2286Cell
Lu99ACell类似产品::B16-F1Cell、Renal CarcinomaCell、MBT2Cell
SK-N-SHCell类似产品::Moorfields/Institute of Ophthalmology-Muller 1Cell、DMS-79Cell、STC-1Cell
RCCJFCell类似产品::HSC-1Cell、UMUC1Cell、CLONE M3Cell
CCRF SBCell类似产品::H-1355Cell、KTCTL-140Cell、A101DCell
RT4Cell类似产品::U-118-MGCell、OLN 93Cell、SVOGCell
RLE-6TNCell类似产品::C3H10T1/2CL8Cell、U-251MGCell、RWPE-1Cell
GM04154BCell类似产品::CG-4Cell、HCV-29Cell、SNU-354Cell
HLE-B3Cell类似产品::2PK-3Cell、HTSMCCell、RPE-hTERTCell
NCIH1993Cell类似产品::3AACell、KPL4Cell、HUV-EC-CCell
IGROVCell类似产品::HCT8Cell、NFHIOSE-80Cell、PA-1Cell
MDA361Cell类似产品::HCC0038Cell、RCC 786-OCell、QG56Cell
COLO-357Cell类似产品::SNU449Cell、S91Cell、MM1.SCell
PANC0813Cell类似产品::293c18Cell、P3/agCell、BRL-3ACell
NCI N87Cell类似产品::MGC-803Cell、MV4-11Cell、NCIH208Cell
ID8 Cells|小鼠卵巢癌需消化细胞系
Calu-3Cell类似产品::H-378Cell、OP-9Cell、Hs 611.TCell
Caov-3Cell类似产品::BLO 11Cell、LUDLU 1Cell、SUM-52Cell
LL/2Cell类似产品::MDA-436Cell、TCCPAN2Cell、BEP2DCell
NCIH810Cell类似产品::NCI-H2126Cell、NFHIOSE-29Cell、LS513Cell
FHL-124Cell类似产品::SK-MEL3Cell、SkChA-1Cell、LUDLU1Cell
H-II-E-C3Cell类似产品::beta-TC6Cell、MDCK-2Cell、NE1Cell
LA-4 [Mouse lung adenoma]Cell类似产品::H2347Cell、DSL-6A-C1Cell、RIMECCell
NCIH2073Cell类似产品::BCECsCell、L23/PCell、ECC1Cell
COLO-680NCell类似产品::HEK-293FTCell、KP 4Cell、HGSMCCell
SW1222Cell类似产品::HRA 19Cell、Normal Rat Kidney-49FCell、HCC941122Cell
NCI-H102Cell类似产品::KHYG1Cell、B/C3T3Cell、WIL2 SCell
Hs737TCell类似产品::KLN 205Cell、MDAMB468Cell、HACell
639-VCell类似产品::PA-TU-8988SCell、CAL27Cell、NCI-H1435Cell
MT-2JCell类似产品::SKNASCell、FUOV1Cell、293/EBNACell
C41Cell类似产品::HEK293-ACell、C2ACell、EMT6Cell
HOCCell类似产品::H-2073Cell、293SCell、H1648Cell
EFO27Cell类似产品::NCIH2171Cell、H1417Cell、Balb/c 3T3Cell
T 98 GCell类似产品::FHs74IntCell、MLA144Cell、MPC-83Cell
H1666_DACell类似产品::RK13Cell、NCI-SNU-387Cell、AROCell
CEM/0Cells;Cell背景资料:G.E. Foley 等建立了类淋巴母CellCell株CCRF-CEM。 Cell是1964年11月从一位四岁白女性急性淋巴Cell白血病患者的外周血白血球衣中得到。此Cell系从香港收集而来。;Cell传代方法:1:2传代。3天内可长满。;Cell生长特性:悬浮生长;Cell形态特性:淋巴母Cell样;相关Cell有:NCI-H1734Cells、GM01232ECells、NTera-2D1Cell
OVCAR432Cells;Cell背景资料:详见相关文献介绍;Cell传代方法:1:2-1:3传代;每周换液2-3次。;Cell生长特性:贴壁或悬浮,详见Cell说明书部分;Cell形态特性:详见Cell说明书;相关Cell有:LU-65MCells、Malme-3MCells、H-2030Cell
BIC1Cells;Cell背景资料:食管腺癌;男性;Cell传代方法:1:2-1:3传代;每周换液2-3次。;Cell生长特性:贴壁;Cell形态特性:详见Cell说明书;相关Cell有:NCI-H1048Cells、TR 146Cells、AHH-1Cell
SP2-0-Ag14Cells;Cell背景资料:该Cell是由绵羊红Cell免疫的BALB/c小鼠脾Cell和P3X63Ag8骨髓瘤Cell融合得到的。该Cell不分泌免疫球蛋白,对20μg/ml的8-氮鸟嘌呤有抗性,对HAT比较敏感;该Cell可以作为Cell融合时的BCell组分用于制备杂交瘤;鼠痘病毒阴性。;Cell传代方法:1:2传代;Cell生长特性:悬浮生长;Cell形态特性:淋巴母Cell样;圆形;相关Cell有:KNS-81Cells、ToledoCells、MHH-CALL2Cell
BT-474Cells;Cell背景资料:详见相关文献介绍;Cell传代方法:1:2-1:3传代;每周换液2-3次。;Cell生长特性:贴壁或悬浮,详见Cell说明书部分;Cell形态特性:详见Cell说明书;相关Cell有:T-47-DCells、Ly10Cells、BC-028Cell
UM-UC14Cells;Cell背景资料:肾癌;男性;Cell传代方法:1:2-1:3传代;每周换液2-3次。;Cell生长特性:贴壁;Cell形态特性:详见Cell说明书;相关Cell有:NCIH510Cells、OVCAR 8Cells、Psi2-DAPCell
SVGp12Cells;Cell背景资料:星形胶质Cells;SV40转化;男性;Cell传代方法:1:2-1:3传代;每周换液2-3次。;Cell生长特性:贴壁;Cell形态特性:详见Cell说明书;相关Cell有:H-2066Cells、SW-1573Cells、TE354TCell
KYSE510Cells;Cell背景资料:食管鳞癌;女性;Cell传代方法:1:2-1:3传代;每周换液2-3次。;Cell生长特性:贴壁;Cell形态特性:详见Cell说明书;相关Cell有:Eph4 1424Cells、AE1201Cells、Ramos 2G6.4C10Cell
C-127Cells;Cell背景资料:详见相关文献介绍;Cell传代方法:1:2-1:3传代;每周换液2-3次。;Cell生长特性:贴壁或悬浮,详见Cell说明书部分;Cell形态特性:详见Cell说明书;相关Cell有:McARH7777Cells、TOV112Cells、BPH-1Cell
OCI-AML4Cells;Cell背景资料:急性髓系白血病;女性;Cell传代方法:1:2-1:3传代;每周换液2-3次。;Cell生长特性:悬浮;Cell形态特性:详见Cell说明书;相关Cell有:HCC-94Cells、F36PCells、Colo320Cell
ISHICells;Cell背景资料:详见相关文献介绍;Cell传代方法:1:3传代,3-4天换液一次;Cell生长特性:贴壁生长;Cell形态特性:上皮样;相关Cell有:SF17Cells、MC-26Cells、NCI-SNU-387Cell
EJ-1Cells;Cell背景资料:详见相关文献介绍;Cell传代方法:1:2-1:3传代;每周换液2-3次。;Cell生长特性:贴壁或悬浮,详见Cell说明书部分;Cell形态特性:详见Cell说明书;相关Cell有:Functional Liver Cell-7Cells、FHCRC subclone 11Cells、Cor L88Cell
DMS 153Cells;Cell背景资料:详见相关文献介绍;Cell传代方法:1:2-1:3传代;每周换液2-3次。;Cell生长特性:贴壁或悬浮,详见Cell说明书部分;Cell形态特性:详见Cell说明书;相关Cell有:Hs852TCells、CHOCells、T/G HA VSMCCell
DU-145Cells;Cell背景资料:DU 145 是从一位有3年淋巴Cell白血病史的前列腺癌患者的脑部转移灶中建立的。该Cell系未检测到激素敏感性,酸性酶阳性,单个的Cell可在软琼脂中形成集落。对此Cell和原始肿瘤的亚显微结构分析可见微绒毛、微丝、Cell桥粒、线粒体、发达的高尔基体和异质溶酶体。该Cell不表达前列腺抗原。;Cell传代方法:1:2-1:3传代;每周换液2-3次。;Cell生长特性:贴壁;Cell形态特性:上皮Cell样;相关Cell有:HRGECCells、Human Pancreatic Duct EpithelialCells、Hx-147Cell
Oregon J-111Cells;Cell背景资料:单核Cell白血病;Cell传代方法:1:2-1:3传代;每周换液2-3次。;Cell生长特性:悬浮;Cell形态特性:详见Cell说明书;相关Cell有:RGC6Cells、hTERT-HME1Cells、ARIPCell
MGSMCCells;Cell背景资料:详见相关文献介绍;Cell传代方法:1:2-1:3传代;每周换液2-3次。;Cell生长特性:贴壁或悬浮,详见Cell说明书部分;Cell形态特性:详见Cell说明书;相关Cell有:WM 115Cells、Hs675Cells、16HBE14o-Cell
B16-F0Cells;Cell背景资料:详见相关文献介绍;Cell传代方法:1:2-1:3传代;每周换液2-3次。;Cell生长特性:贴壁或悬浮,详见Cell说明书部分;Cell形态特性:详见Cell说明书;相关Cell有:Hs737TCells、AKCells、HOECCell
HCGCCells;Cell背景资料:小脑;颗粒Cells;Cell传代方法:1:2-1:3传代;每周换液2-3次。;Cell生长特性:贴壁;Cell形态特性:详见Cell说明书;相关Cell有:BC3H-1Cells、PG-BE1Cells、OCUM-1Cell
SW403Cell类似产品::V-79Cell、no-11Cell、6T-CEMCell
S37Cell类似产品::HBE135-E6E7Cell、Jurkat, Clone E6-1Cell、NCIH716Cell
NCI-H441Cell类似产品::HCC-366Cell、MN 60Cell、DITNC1Cell
OCI-LY-1Cell类似产品::Hs 445Cell、L6Cell、SMMC7721Cell
U343MGCell类似产品::JM-JurkatCell、RPMI 1788Cell、U87-MGCell
MinkCell类似产品::ROS 17/28Cell、SUIT2Cell、Human Microglia Clone 3Cell
PC3M-1E8Cell类似产品::CEMx721.174.T2Cell、MC3T3-E1 Subclone 4Cell、Hs839.TCell
NCI.H226Cell类似产品::HEC1-BCell、5-8FCell、NCI H508Cell
KATO IIICell类似产品::MES 23.5Cell、PLC8024Cell、TGW-I-nuCell
CaES-17Cell类似产品::MDA453Cell、MNNGHOSCell、H211Cell
HCC38Cell类似产品::NCI-H2171Cell、Hs 766.TCell、MGC803Cell
8505CCell类似产品::BGC823Cell、NCI-H1930Cell、Danio rerio GillCell
SK-N-BE2Cell类似产品::SNT8Cell、NCI-H676BCell、SUM159Cell
WEHI-3BCell类似产品::Okayama University Medical School-23Cell、H1385Cell、GA-10-Clone-4Cell
MDA134Cell类似产品::RBL 1Cell、H-1993Cell、MDCKCell
HPAFCell类似产品::Hs 729Cell、SKMEL-24Cell、SNK1Cell
M-20Cell类似产品::HCCC9810Cell、CAL148Cell、MUVECCell
BALB/3T3Cell类似产品::GM03573Cell、HEL 92.1.7Cell、T9Cell
SNU251Cell类似产品::LS 513Cell、L-Wnt-3ACell、AN3-CACell
HBZY1Cell类似产品::VeroE6Cell、Mac-1Cell、LS 174TCell
QGP 1Cell类似产品::H-35Cell、LTEPsmCell、CATH.aCell
Hepa-RGCell类似产品::SF 763Cell、DHL4Cell、NCIH1373Cell
CCRF-CEM C1Cell类似产品::HIMECCell、FaDuCell、HCT-GEOCell
C-4ICell类似产品::BMFCell、YH-13Cell、Pa18CCell
HFL 1Cell类似产品::MIA Paca2Cell、Panc 04.03Cell、HCC-1937Cell
PANC-1Cell类似产品::HIEC-6Cell、HIT T15Cell、Leghorn Male Hepatoma cell lineCell
RPMI6666Cell类似产品::CCRF/CEM-C7Cell、MPP89Cell、DH 82Cell
HRA19Cell类似产品::UMNSAH-DF1Cell、SW-1463Cell、IGROV1Cell
MDA 231-LM2-4175Cell类似产品::University of Michigan-Urothelial Carcinoma-14Cell、Ca761Cell、H719Cell
ID8 Cells|小鼠卵巢癌需消化细胞系
Kit 225-K6Cell类似产品::3T3-F442ACell、PIECCell、SK-MEL-3Cell
PL45Cell类似产品::4T1Cell、NHDFCell、Centre Antoine Lacassagne-12TCell
PC615.3Cell类似产品::HCC827Cell、LIM1215Cell、BEL7402Cell
LoVoCell类似产品::KYSE 270Cell、SNU878Cell、NCI-H1105Cell
Human Foreskin FibroblastCell类似产品::STC-1Cell、TE-85Cell、CF PAC-1Cell
OVHMCell类似产品::MV-522Cell、NCIH2291Cell、GP2-293Cell
MHCC 97-HCell类似产品::NIT-1Cell、Tn-5B1-4Cell、MADISON LUNG TA-109Cell
NCIH740Cell类似产品::FU-97Cell、TTCell、SK-OV-433Cell
"